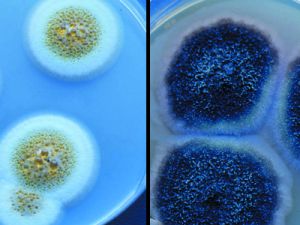
351big_pic14.jpg

Farby należą do grupy atakowanej przez mikroorganizmy. Natężenie inwazji i szkody wyrządzone rozkładają się w różny sposób, w zależności od stanu skupienia farby i grupy mikroorganizmów. Największe zagrożenie dla farb stanowią bakterie, grzyby i pleśń.
Grzyby atakują farby przede wszystkim w stanie suchym, w postaci powłok malarskich, natomiast są mniejszym zagrożeniem dla farb wodorozcieńczalnych w stanie płynnym. Agresywnymi w stosunku do farb są bakterie, lecz te stwarzają groźbę głównie dla farb wodorozcieńczalnych w stanie płynnym. Na suchych powierzchniach malarskich bakterie występują jedynie jako zagrożenie dla otoczenia, nie powodując szkód w samym podłożu.
Algi występują praktycznie jedynie na powłokach malarskich zewnętrznych, w miejscach zazwyczaj zacienionych i bardzo wilgotnych, pogarszając estetykę zewnętrzną budynku, lecz z racji warunków swej wegetacji, wraz z nimi pojawiają się również kolonie grzybów. Algi nie występują w zamkniętych opakowaniach farby ze względu na brak dostępu światła dziennego.
Natomiast zagrożeniem dla farb w stanie płynnym są głównie bakterie i okazjonalnie grzyby oraz drożdże. Przedmiotem inwazji są głównie farby wodorozcieńczalne, posiadające w swym składzie chemicznym tak wodę, jak i substancje organiczne stanowiące pożywkę. Jeśli dopuścimy do zainfekowania płynnej farby bakteriami lub grzybami, pozwalając na rozwój ich wegetacji, możemy oczekiwać pojawienia się problemów w postaci:• utraty lepkości farby
• pojawienia się nieprzyjemnego odoru
• możliwej zmiany barwy
• gazowania
• rozdzielania składników
• spieniania
• sedymentacji
• zmiany pH.

Grzyby pleśniowe i ich zarodniki w powiększeniu. Źródło: www.epa.gov
Jedynym sposobem uniknięcia problemu zatrucia mikrobiologicznego farby jest zespół przedsięwzięć polegający na:
• stosowaniu skutecznych zabezpieczeń mikrobiologicznych dla zawartości opakowania,• dokładnej kontroli mikrobiologicznej surowców, półwyrobów, wody, opakowań i procesu produkcyjnego,
• prewencja ze strony producenta jest jedynym sposobem uniknięcia zniszczenia farby.
Mikroorganizmy nie są widoczne gołym okiem, a dostrzeżenie skutków ich działania jest już płaczem nad rozlanym mlekiem. Niezmiernie ważna jest więc higiena produkcji. W tej sytuacji jedynym logicznym rozwiązaniem jest systematyczna kontrola atmosfery wokół linii produkcyjnej i okresowe jej oczyszczanie metodą gazowania oraz stosowanie ścisłej kontroli mikrobiologicznej obiegu wodnego i opakowań przy pomocy środków bakteriobójczych o długotrwałym działaniu. Surowce powinny być traktowane środkami biobójczymi o błyskawicznym działaniu. Do przedsięwzięć tych należy stosować środki bakteriobójcze sprawdzone, pochodzące od uznanych producentów. Tego typu problemy pojawiają się głównie u producentów farb budowlanych, gdzie większość wyrobów należy do grupy wodorozcieńczalnych. Jeśli w fabryce nie ma dostatecznie dokładnej kontroli wody i surowców, a higiena procesu nie jest wysokiej jakości, zatrucie może być rozpowszechnione i pojawi się generalny problem jakości wyrobów danego producenta. Stabilność jakościowa musi być zapewniona na cały okres gwarancyjny farby, a nawet na przypadek częściowego użycia opakowania i ponownego użycia po okresowym przechowywaniu uprzednio otwartej puszki.






